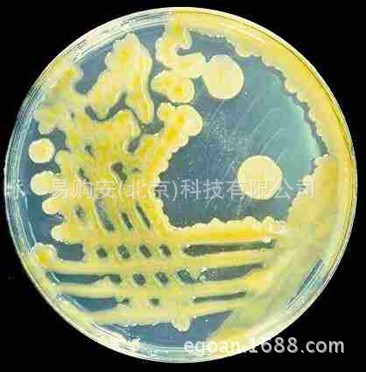

1688工业品为您提供在线免费查询更多实验仪器装置详细参数、实时报价、规格一览表。更多关于实验仪器装置多少钱一台/实验仪器装置报价明细/实验仪器装置规格型号价格表/实验仪器装置批发市场价格/实验仪器装置官方报价等咨询,尽在1688工业品。询底价>
为你找到其他实验仪器装置相关产品

多点接种仪HMI-60&24
北京
在线询价

配套屹尧15位WX-8000微波消解罐/副罐-新款上架
江苏南京
在线询价

QCJ漆膜冲击器
陕西西安
在线询价

FRC-100KV阻容分压器
上海
在线询价

100*100*100立方单只单联混凝土抗压试模,试块模磨具盒子塑料铸铁

上海
在线询价
菌株(克雷白氏杆菌(KLEBSLELLA))
北京
在线询价

海门其林贝尔VORTEX-5实验旋涡混合器VORTEX-6光控旋涡混合器
北京
在线询价

CUTLAM Cutting liquid 721型 切割冷却液进口古莎Kulzer上海弘测
上海
在线询价

单面制备器,油漆涂料试验仪器
天津
在线询价

销售供应 澳大利亚进口Cryologic CL3300程序降温仪 细胞冷冻仪器
广东广州
在线询价

interscience 全自动菌落计数器 Scan 500电子精准高效多功能
上海
在线询价

WGX-2020高温恒温循环槽
江苏南京
在线询价
查看更多产品及报价
100+其他实验仪器装置相关产品等你解锁
在线寻源3000行家正在找货
免费询价,源头正品,上1688工业品,全国的工业正品交易平台





